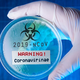

Zdravniška zbornica predlaga, da vstopne točke organizira NIJZ in v njih izvaja preglede ter usmerja paciente

Po izjavah Ministrstva za zdravje naj bi se v Sloveniji v primeru izbruha epidemije koronavirusa SARS-CoV-2 (COVID-19).vzpostavilo 55 vstopnih točk, in...
Dolenjski list · 5L
Zdravniška zbornica za organizacijo vstopnih točk za koronavirus na območnih enotah NIJZ

V Zdravniški zbornici Slovenije so kritični do načrta za vzpostavitev 55 vstopnih točk na primarni ravni za primer epidemije novega koronavirusa. Taka rešitev bi po njihovo vodila v nenadzorovano širjenje …
![]() Primorske novice · 5L
Primorske novice · 5L
Zdravniki se sprašujejo: če pacient ne bo ubogal, naj pokličemo policijo?

Zdravniška zbornica opozarja na neprimerne ukrepe, ki jih je pripravilo ministrstvo. V Zdravniški zbornici Slovenije še naprej z zaskrbljenostjo spremljajo organiziranje zdravstvene oskrbe v primeru izbruha epidemije koronavirusa sars-cov-2 (covid-19), …
Slovenske novice · 5L
Zdravniška zbornica z zaskrbljenostjo spremlja dogajanje

Sporočajo, da rešitev ministrstva za zdravje, da vzpostavi 55 vstopnih točk ni ustrezna. Ljubljana - V Zdravniški zbornici Slovenije še naprej z zaskrbljenostjo spremljajo organiziranje zdravstvene oskrbe v primeru izbruha …
![]() Delo · 5L
Delo · 5L
Zdravniška zbornica: Aktivno vlogo naj prevzamejo epidemiologi NIJZ
Vstopne točke v okviru nujne medicinske pomoči v zdravstvenih domovih niso najboljša rešitev, pravijo v zdravniški zbornici, kjer predlagajo, da se omenjene točke vzpostavi v okviru območnih enot NIJZ, kjer …
![]() 24ur · 5L
24ur · 5L
Z obiskom in uporabo spletnega mesta soglašate s piškotki.